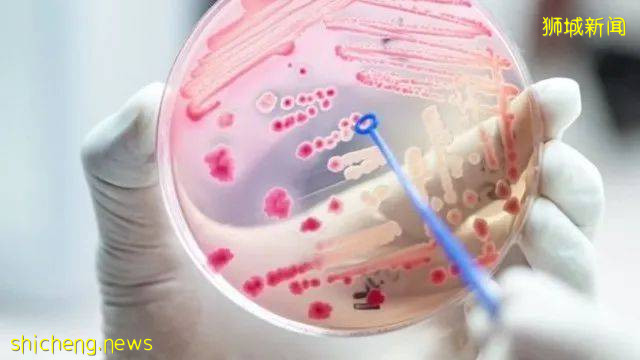
新加坡开发出一套测试模式,五分钟内计算出败血症死亡风险

新加坡开发出一套测试模式,五分钟内计算出败血症死亡风险
新加坡中央医院和杜克—新加坡国立大学医学院合作,运用人工智能开发出一套能评估败血症死亡风险的预测模式,能在五分钟内准确计算出病人的死亡风险。
中央医院的紧急部门每年平均为超过1000名败血症病人提供治疗,而新加坡在2019年有将近5000人死于肺炎和尿道感染引发的败血症。

(图片来源网络)
一般上,验血是评估败血症死亡风险的最准确方式,但验血报告通常需要两到四个小时的时间出炉,这可能延误病人的治疗。
有鉴于此,研究人员分析了中央医院紧急部门340名败血症病人的资料,根并据这些病人的呼吸率、血氧浓度以及心率变异分析数据开发出一套模式,能在五分钟内计算出同败血症相关的死亡风险。
(图片来源网络)
为了进一步评估这套模式的准确度,研究团队目前正在中央医院和国大医院展开更大规模的研究,参与的病人达到1100人。
研究团队也正在评估这项科技是否能研发成一台设备,放置在紧急部门、专科诊所、家庭诊所甚至一般住家内,作为监督病人健康情况的器材。
评论